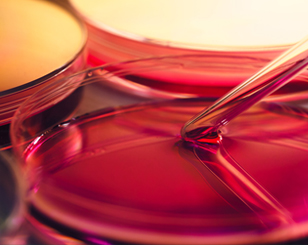
태반 주사

- ウェルエイジングビタミン栄養注射(IV nutritional treatment)
-
血管注射によるウェルエイジング治療
老化を防ぐ抗酸化作用
不足しやすい栄養素を補充して身体機能を向上
ウェルエイジングビタミン注射
明るくて弾力のある肌と老化防止は、活性酸素除去(抗酸化)から始まります。
チャン皮膚科のウェルエイジングビタミン注射はビタミン、
抗酸化成分など私たちの体に必要な栄養成分を血管注射で直接補充して肌だけでなく全身機能を改善させて、
より健康な状態を維持するウェルエイジング治療です。
ウェルエイジング専門のチャン皮膚科の
皮膚治療と共にする抗酸化ビタミン注射
スリム&ホワイト

- 白玉注射
-
グルタチオン(glutathione)成分、細胞内の重要な抗酸化剤として抗酸化作用、美白作用、肝解毒作用(デトックス)を行い、
疲労回復、脱毛緩和、ストレス緩和、老化防止の効果があります。

- シンデレラ注射
-
α-リポ酸成分はビタミンC、Eの400倍に当たる抗酸化力を持っていて、体内の有害(活性)酸素を抑制する効果で老化を防ぎ、エネルギー消費を促進して体脂肪減少に役立ちます。また疲労回復、肌改善効果があります。

- メガビタミン注射
-
大容量ビタミンC成分で、肌の美白、老化防止、弾力回復、免疫力強化、傷回復、弾力回復、老化防止、ストレス/疲労回復、体力強化の効果があります。

- スリム&ホワイトカクテル
-
白玉、シンデレラ、メガビタミンをミックスしてより強力な美白、ダイエット効果を発揮します。
ウェルエイジング&エナジャイジング
- プラセンタ注射
-
胎盤の豊富な栄養素と成長因子が含まれていて、肌の弾力改善、肝機能改善、更年期症状改善、疲労回復、老化防止、関節炎、神経痛の改善効果を持ちます。

- ニンニク注射
-
フルスルチアミン(ビタミンB1)成分で、素早い疲労回復、体力強化、皮膚改善、ストレス回復、筋肉痛、関節痛改善、老化防止効果があります。

- 甘草(カンゾウ)注射
-
甘草エキスのグリチルリチン、システイン-グリシン成分で、肌美白、抗老化、抗アレルギー、解毒作用、疲労回復、肝機能改善、免疫力強化、皮膚改善、脱毛防止の効果を持ちます。

- ビタミンD
-
免疫力強化、カルシウムとリン代謝調節、骨強化、細胞成長、筋肉発達など私たちの体の多様な機能を強化します。
ウェルエイジング血管注射、こんな方におすすめします。
抗老化注射、こんな方におすすめします。
- · 肌トーンが暗く明るくなりたい方
- · 弾力が落ちたと感じる方
- · 肌が乾燥して引っ張られる方
- · 抜け毛の本数が多い方
- · 顔が疲れて見える方
- · 日光浴の露出が少なくビタミンDの補給が必要な方
- · いくら休んでも疲れが取れない方
- · 更年期障害の方
- · 仕事でお酒をよく飲む方
- · 風邪によく引いたり、免疫力が落ちたと思う方
- · 食事で栄養を満たしていないと感じる方
- · 体重減量をしている方
- · 栄養素不足が気になる方
- · 減量に役立つ治療を受けたい方
ウェルエイジングビタミン注射Q&A
Qビタミン注射、何回くらい打ったほうがいいですか?
A
初期には週1~2回、10~20回の治療を推奨しています。効果の実感ができると頻度を増やして効果を維持することをお勧めします。
Q副作用はないでしょうか?
A
抗老化注射の成分は、私たちの体に必須な栄養素として十分に検証された安全な成分です。薬物によっては注射時に血管痛などの不便感がある場合はありますが、過量投与は避けて適切な用量をお勧めします。
Q飲むサプリメントとは何が違うんですか?
A
栄養素は食べ物やサプリメントでも摂取できますが、胃腸管を通じて吸収される量が少なく、十分な血中濃度に達するのが難しいです。したがって、静脈栄養注射療法は、素早く十分な量の栄養素を血液に直接注入して確実に効果を高める方法です。
チャン皮膚科ウェルエイジングセンター

- ウェルエイジング
-
ネチュラルで健康的な美しさを取り戻して、維持するために老化を戻し、遅らせる治療をします。

- 抗老化リフティングの専門家
-
国際的な学会、講演、学術活動・研究を通じて皮膚科の専門医が最新の皮膚科学に基づいて治療します。

- 最適化されたオーダーメード治療
-
老化の程度とタイプ、ライフスタイルを考慮して個人別に最適化されたオーダーメード治療をお勧めします。

- 未来の自分を考慮した治療
-
10年、20年後の全生涯を考慮して、長期的に美しく歳を取るように治療を計画します。

- 様々な施術と装備
-
各施術の長所と短所を考慮して、お客様に必ず必要な施術を選択、組み合わせて治療します。
5つの施術原則
チャン皮膚科の施術原則
- 01.
-
正確な診断に基づいて、個々の特徴に合わせてカスタマイズ治療を行います。
-
- 03.
-
安全を最優先にして最適な効果を生み出します
- 04.
-
人為的でやりすぎないネチュラルな結果を追求します。
- 05.
-
信頼をもとに装備/消耗品/薬物などは許可された正規品のみを使用します。